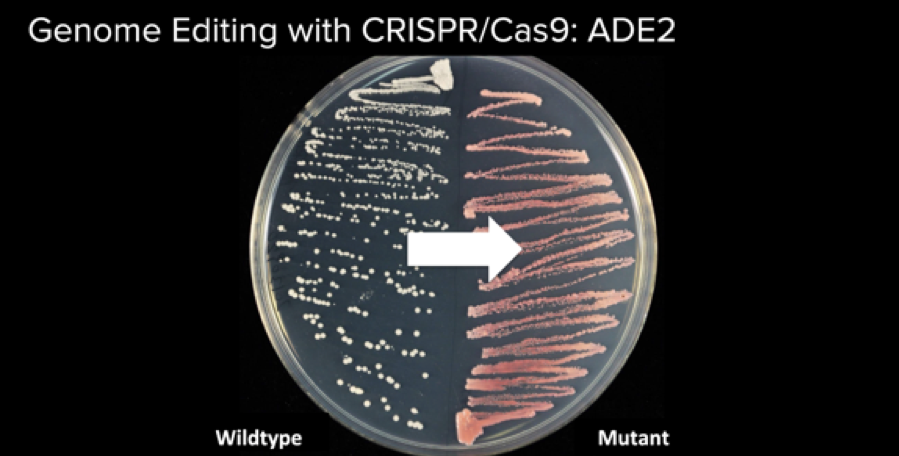
White_to_Red
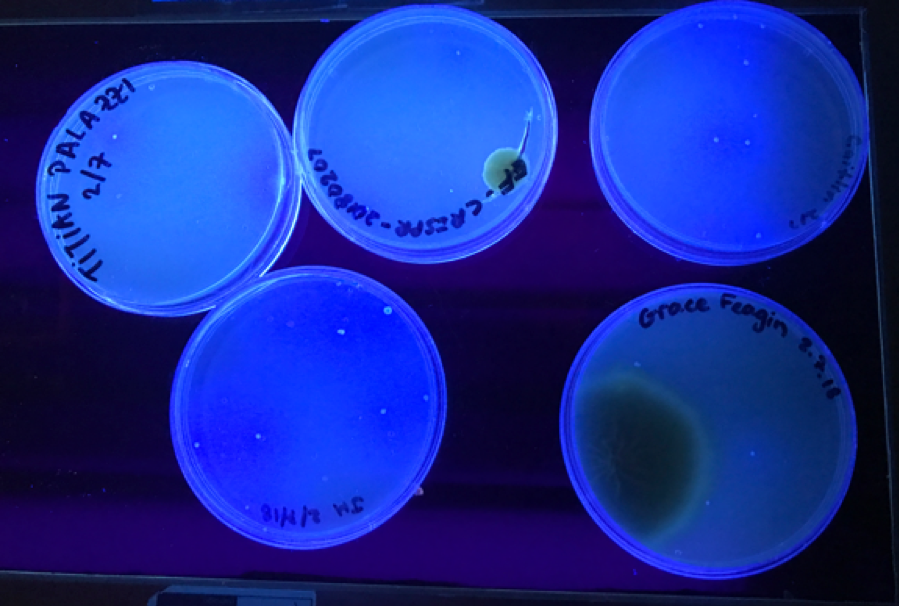
Petri_Dishes_CRISPR

Welcome to my annual book review. See prior versions here: 2024, 2023, 2022, 2021, 2020, 2019, 2016, 2015, and all time.
In 2024, I set two intentions: to consider alternatives to reading books for the purpose of learning (e.g. YouTube, ChatGPT) and to pair reading with action. I picked up a few books this year because they were immediately relevant, and then paired reading those books with action. For example, I used the principles of The Mom Test in customer discovery, and paired Meeting The Shadow with a few therapy sessions to explore my “shadow side”.
In 2025, I will continue to read books for their direct application. I also plan to pick up at least a few books that have stood the test of time that simply interest me for the sake of curiosity and cultivating a long attention span (e.g. The Power Broker or The Making of the Atomic Bomb).
I finished 25 books this year. For the full list, check out my Goodreads. On to my top picks for 2025.

Freedom’s Forge
This is an amazing history book on WW2. Its main premise: the Allies won WW2 because of the industrial production machine, which was built by American private industry. (Hence the book’s subtitle: How American Business Produced Victory In World War II.)
This story is told through the lives of two protagonists. Bill Knudsen was a former executive at Ford who became President of General Motors under Chairman Alfred Sloan and later led the Office of Production Management. Henry Kaiser was the legendary founder of a large engineering and construction firm known as The Six Companies that built some of the largest Depression-era dams (including Hoover Dam) and built ports, ships, and provided cement during WW2.
Reading this book got me excited about the ability for business to be a force for good. The book shows how business executives unlocked the American production machine and in doing so defeated the Nazis. It was put well by Stalin in his first meeting with Churchill and Roosevelt in Tehran in 1943 in a toast, “to American production, without which this war would have been lost.”
This book reminds me of Pieces of the Action, about Vanevar Bush’s role in in WW2. I found this book more thrilling.
Circe
This is easily one of the best fiction books I’ve read in recent years. I read Miller’s other book, Song of Achilles, in 2024. It’s equally good. Both books are modern retellings of Greek mythology.
Circe includes the tales of the Titans, Prometheus, Odysseus and the Trojan War, Scylla, Daedalus and Icarus, Minos and the Minotaur, and many more. The book is a story about fear and love, good and bad, life and death.
Miller’s writing is beautiful without being flowery (e.g. “But I pressed his face into my mind, as seals are pressed in wax, so I could carry it with me.”)
As One Is
This book, a collection of six talks given by Krishnamurti in Ojai, California in the 1950s, makes you uncomfortable. The book’s subtitle says it all: “to free the mind from all conditioning”.
Krishnamurti reminds you that you live in a mirage if you are not fully present. He writes provocatively, challenging assumptions. This book is worth returning too; it’s best read a few pages at a time. As Krishnamurti advises in almost every talk, “don’t just hear the words, try to validate what I say with your own experience”.
I also listened to Eckhart Tolle’s The Power of Now this year, which has a similar message: be here now. I would recommend that book too.
Project Hail Mary
This is a riveting sci-fi book about a human astronaut on a journey to save humanity who becomes allies with an alien. It was a real page-turner. I enjoyed how the author had two plots that developed in the opposite chronological order (one forwards in time; the other backwards).
Some of the interesting ideas explored in this book: a life form (astrophage) that takes energy from the sun and is incredibly energy-dense; an alien language based on sound, not light (think of bats); a counting system in base 6, rather than base 10; a culture around watching each other sleep but not watching each other eat.
On sci-fi, I also read Children of Time this year (which I found to be less gripping) and Daemon (which was a lot more dystopian). I still think The Three Body Problem is one of the best sci-fi books I read in the last few years.
I also really enjoyed reading “If the universe is teeming with aliens… where is everybody”, which includes fifty possible explanations to the Fermi paradox.
Skunkworks
This book was recommended by my friend Damien. It tells the story of how Lockheed’s Skunk Works developed some of the most innovative aircraft of the 20th century: the Stealth Fighter used in Operation Desert Storm (F-117A), the SR-71 (Blackbird), and the U-2 spy plane.
The story is told from the perspective of Ben Rich, who took over as CEO from the founder of Skunk Works, Kelly Johnson. The chapters are interspersed with perspectives from others, titled “Other Voices”.
This book gets you all fired up about building, similar to How Big Things Get Done, Freedom’s Forge, or The Founders (about Paypal).
Creatiespiraal
As far as I know, this book is available only in Dutch. It was recommended by my friend Steven Blom. The book introduces a cycle of creation, loosely inspired by Joseph Campbell’s hero’s journey. I found it incredibly helpful to read this as I took a period of rest (sabbatical) and I’m exploring my next adventure. I would recommend this book to anyone who reads Dutch.





 Screenshot from
Screenshot from Our goal was to turn yeast from its natural white color (left) to red (right). Photo courtesy of Will Shindel, Genspace’s instructor.
Our goal was to turn yeast from its natural white color (left) to red (right). Photo courtesy of Will Shindel, Genspace’s instructor.  Screenshot of CRISPRdirect, a website that helps you to identify the guide RNA sequence with the highest likelihood of cutting your gene successfully.
Screenshot of CRISPRdirect, a website that helps you to identify the guide RNA sequence with the highest likelihood of cutting your gene successfully.  The blue, double strand is the original DNA; the purple, single strand of DNA is the inserted genetic material. This screenshot shows how the purple, new DNA is being connected with the outermost 4 base pairs onto the blue, original DNA.
The blue, double strand is the original DNA; the purple, single strand of DNA is the inserted genetic material. This screenshot shows how the purple, new DNA is being connected with the outermost 4 base pairs onto the blue, original DNA. Petri dishes with yeast colonies under UV light. The petri dish top-center and bottom-right show mold growth (this is contamination).
Petri dishes with yeast colonies under UV light. The petri dish top-center and bottom-right show mold growth (this is contamination). 








